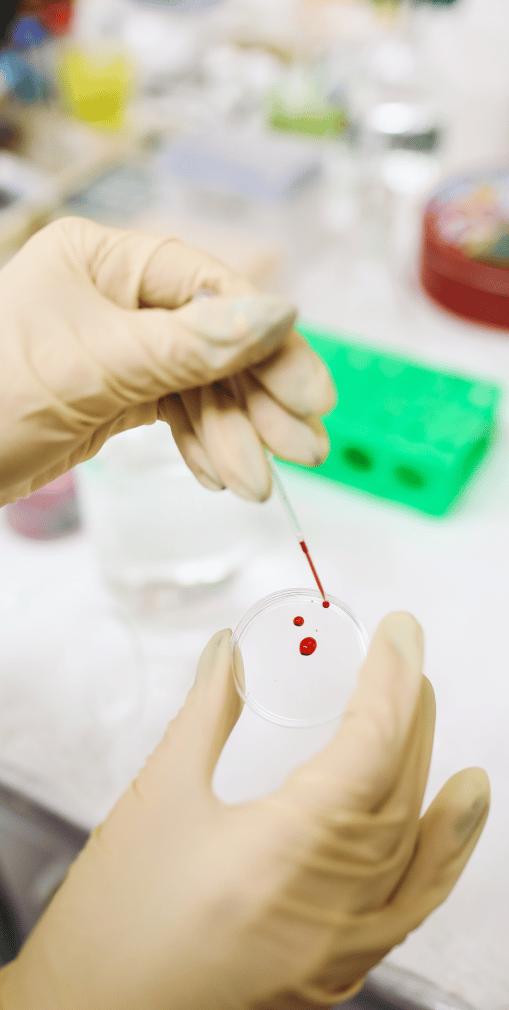
Doctor testing blood on a Petri dish

Mesothelioma Clinical Trials
Mesothelioma is a rare and devastating form of cancer. It often has a poor prognosis despite an aggressive treatment plan. Clinical trials help researchers learn more about the cancer and how to treat it effectively. It involves testing research methods on real-world mesothelioma patients, which may include experimental drugs and treatment protocols.
Home » Leading National Mesothelioma Law Firm » Mesothelioma Cancer » Mesothelioma Treatment » Mesothelioma Clinical Trials
Navigate This Page
- What Are Clinical Trials?
- How Do Clinical Trials Work?
- Where Can I Learn About Available Clinical Trials?
- Who Is Eligible To Participate in a Mesothelioma Clinical Trial?
- Available Clinical Trials for Mesothelioma Patients
- Are Clinical Trials Safe?
- Considerations Before Participating in a Study
- What if My Condition Worsens During the Study?
- Do I Have Options if I Do Not Meet the Eligibility Criteria for Current Clinical Studies?
- Are Clinical Trials Ever Successful?
Patients with pleural mesothelioma, the most common form of the disease, have a median life expectancy of just 15 to 22 months with standard treatment. This dire prognosis often motivates mesothelioma patients to look for alternative treatment options. Clinical trials provide mesothelioma patients with hope, especially for patients whose specific cases have left them with limited treatment options.
What Are Clinical Trials?
Clinical trials are FDA-regulated research studies that test experimental new drugs and treatment protocols on human volunteers. They are funded by both public agencies and private institutions, such as universities. The leader of a clinical study, often a doctor, is known as the principal investigator, and the entity funding each study is the sponsor.

How Do Clinical Trials Work?
Clinical trials are used to increase medical knowledge and test treatment in response to research findings. The two primary types of clinical trials are observational and interventional. In observational studies, investigators assess health outcomes that stem from interventions, but participants are not assigned interventions via the study.
Interventional clinical studies test treatment protocols through controlled studies.
What Is the Goal of Clinical Trials?
The goal of clinical trials is to identify safe and effective treatments that can ultimately receive FDA approval as standard treatments. The approval process requires each clinical trial to complete the following four phases, each of which has its own purpose, according to the M.D. Anderson Cancer Center in Texas:
- Phase 1: Phase 1 clinical trials study an average of 15 to 50 patients and evaluate the following:
- The safety of the treatment
- The best method of delivering treatment
- The lowest effective dose
- Whether the disease or condition responds to treatment
- Phase 2: studies fewer than 100 participants and focus on how effective the treatment is and evaluates side effects
- Phase 3: accepts hundreds of participants and compares the efficacy of new treatments to existing treatments
- Phase 4: accepts thousands of participants to observe the long-term benefits and side effects
Are Some Study Patients Given Placebos?
Placebos, also known as “sugar pills,” are inactive drug treatments used in clinical trials to prevent bias. In double-blind studies, both the participant and the researcher are unaware of whether the participant is receiving a placebo or the active treatment.
According to the American Society of Clinical Oncology, the use of placebos in cancer clinical studies is rare. Utilizing placebos could create ethical concerns if participants receiving placebos do not also receive available standard treatment. Patients participating in placebo-controlled studies must be informed of their use.
If you are considering participating in a placebo-controlled study, it is important to ask the following questions:
Will participants who receive placebos receive an existing treatment during the study?
Does the study design allow control group patients to cross over to the active drug if the cancer progresses during the study?
Where Can I Learn About Available Clinical Trials?
In 1997, Congress passed the Food and Drug Administration Modernization Act (FDAMA). Section 113 of this law required the National Institutes of Health (NIH) to create a publicly accessible clinical trials database with oversight by the FDA. In response, the NIH created ClinicalTrials.gov and expanded it over the years under the guidance of Congress and the FDA.
ClinicalTrials.gov currently lists 65 clinical studies in the United States that are recruiting mesothelioma patients or are in the pre-recruiting stage. Mesothelioma treatment centers often participate in clinical trials and can also provide information about available clinical trials.
Who Is Eligible To Participate in a Mesothelioma Clinical Trial?
Every clinical study sets its own parameters. Some studies evaluate specific types of patients, such as patients of a certain age or with specific symptoms or disease progression. Other studies may be broader. The criteria used can be divided into two types:
- Inclusion criteria: characteristics that a study participant must have
- Exclusion criteria: characteristics that would disqualify a prospective study participant
Available Clinical Trials for Mesothelioma Patients
The interventional clinical studies recruiting or that will recruit participants with mesothelioma in the near future include studies of the following treatment types, as defined by the National Cancer Institute:
- Chemotherapy: drugs to kill or slow the growth of cancer cells
- Immunotherapy: treatments that stimulate the immune system to fight cancer
- Cancer surgery
- Mesothelioma multimodal therapy: a combination of more than one method of treatment
Most clinical trials have several eligibility criteria in common.
Inclusion Criteria
These characteristics are required for eligibility in most mesothelioma clinical trials:
- Sterile or willing to use effective birth control methods
- Over 18 at the time of consent
- Willing to consent to the study protocols, including biopsies, surgical procedures, and drugs
- Blood results within study specifications
- Normal organ and bone marrow function
- An Eastern Cooperative Oncology Group (ECOG) performance status ranging between 0 and 2
- A tumor that can be measured by the Response Evaluation Criteria in
- Solid Tumors standards

Exclusion Criteria
These characteristics disqualify prospective subjects in most mesothelioma clinical trials:
- Known sensitivity to the drugs being tested or the inactive ingredients
- Pregnancy
- Psychiatric or other medical conditions that could adversely impact participation
- Other malignancies or noncancerous diseases in the recent past except for some skin cancers
- Noncancerous health conditions that would increase the risks of treatment
- Individuals who are or may become incarcerated during the study
- History or active cases of HIV, or Hepatitis types B or C, with some studies making exceptions for resolved cases
- Compromised immune systems
- Autoimmune disorders, with exceptions in some studies
- Prior treatment with the same methods or substances
- Concurrent or recent involvement in other clinical studies
- Past recipients of organ or tissue transplantation
- Use of certain medications
- Live vaccination within the past 30 days
Chemotherapy
Olaparib in Patients With Homologous Recombination Deficient Malignant Mesothelioma
This interventional Phase 2 Olaparib trial is available through the University of Chicago Medical Center. The objective is to determine whether the chemotherapy drug Olaparib will help patients’ tumors shrink or stop growing in cases where patients have had gene mutations.
Olaparib, also marketed as Lynparza, is an oral chemotherapy medication that will be given to patients in 28-day cycles. Patients will be present in the clinic on days 1 and 15 upon the initiation of treatment and once every 4 weeks thereafter for as long as treatment continues.
The following outcomes will be measured:
- The percentage of participants whose tumors shrink or stop growing in response to treatment
- The lifespan of patients after taking olaparib
- The length of time patients who take olaparib can live with mesothelioma without progression occurring
- The frequency of side effects
Inclusion Criteria
Participation is limited to patients who meet the following criteria:
- Medical diagnosis of malignant mesothelioma
- BAP1 loss or a genetic mutation in the germ cells or somatic cells that disrupts protein function in at least one gene
- Prior treatment with cisplatin or carboplatin
- Platinum-sensitive disease as evidenced by a lack of disease progression while on a platinum-based chemotherapy drug or for at least three months thereafter
- Life expectancy of 16 weeks or more
- Tumor with at least one lesion that has not previously received radiation treatment and meets size specifications as measured by computed tomography
Exclusion Criteria
Patients with the following characteristics are not eligible:
- Uncontrollable illness
- Platinum-resistant disease
- Uncontrolled, reversible cardiac conditions or congenital long QT syndrome
- Persistent toxicities from previous cancer therapy with the exception of alopecia
- Myelodysplastic syndrome or acute myeloid leukemia
- Brain metastases that cause symptoms
- Spinal cord compression unless treated and clinically stable
- Inability to swallow oral medications or have gastrointestinal disorders that interfere with absorption
Immunotherapy
Brentuximab Vedotin in Treating Patients With CD30+ Malignant Mesothelioma That Cannot Be Removed by Surgery
This interventional Phase 2 Trial of Adcetris (Brentuximab Vedotin) is available through the M.D. Anderson Cancer Center in Houston, Texas. The objective is to determine the efficacy of the monoclonal antibodies brentuximab vedotin in treating patients with CD30-positive malignant mesothelioma that cannot be removed by surgery.
Monoclonal antibodies may interfere with the growth and spread of cancer cells. Participants will receive brentuximab vedotin intravenously over a 30-minute period on day 1 and every 21 days thereafter for as long as disease progression or unacceptable toxicity remains absent.
This study will measure the following:
- The 4-month disease control rate in patients with malignant pleural mesothelioma who are treated with brentuximab vedotin.
- The response rate, progression-free and overall survival rates, safety, and toxicity of brentuximab vedotin
- The incidence of CD30+ expression in malignant mesothelioma during screening and determining its correlation to treatment
Inclusion Criteria
Patients with the following characteristics may be eligible:
- Diagnosis of any type of malignant mesothelioma that is unresectable
- Positive CD30+
Exclusion Criteria
- Radiation therapy to more than 25 percent of the bone marrow
Phase 2 Nivolumab and Ramucirumab for Patients With Previously Treated Mesothelioma
This interventional Phase 2 Nivolumab and Ramucirumab study is available through the following locations:
- Moffitt Cancer Center in Tampa, Florida
- University of Maryland in Baltimore, Maryland
- Karmanos Cancer Center at Wayne State University in Detroit, Michigan
- HealthPartners Institute Regions Cancer Care Center in Minneapolis, Minnesota
The objective of the study is to evaluate the combination of nivolumab and ramucirumab in patients who have previously been treated for mesothelioma. The study will measure the following:
- The response rate
- Adverse events
- Progression-free and overall survival
Inclusion Criteria
- Confirmed inoperable malignant mesothelioma
- A history of at least one pemetrexed-containing chemotherapy regimen
- At least one tumor that qualifies as a targetable lesion
Exclusion Criteria
- Grade 3–4 GI bleeding within the past 3 months
- History of blood clot issues or bleeding disorders
- Cirrhosis above the specified levels
- Poorly controlled hypertension
- Recent history of GI perforation or fistula
- Active brain metastases or cancerous meningitis
- Live vaccination within the past 30 days
- History of interst
Surgery
Phase 2 Trial of Radical Pleurectomy With or Without Intraoperative PDT for Malignant Pleural Mesothelioma
This interventional Phase 2 Radical Pleurectomy Randomized Trial is available in the following locations:
- Roswell Park Buffalo in Buffalo, New York
- Abramson Cancer Center University of Pennsylvania in Philadelphia
The objective is to test whether adding intraoperative Photofrin-mediated photodynamic therapy to radical pleurectomy and post-operative chemo improves patients’ overall survival in patients with epithelioid malignant pleural mesothelioma. This study will measure the following:
- Survival months
- Progression-free survival months
- Local control
- Receipt of pembrolizumab
Inclusion Criteria
- Confirmed diagnosis of the epithelioid type of malignant pleural mesothelioma that is resectable in the opinion of the attending thoracic surgeon
- Disease limited to the hemithorax
Exclusion Criteria
- White blood cell or platelet count below specified limits
- Severe liver disease
- Previously treated with Mantle field radiation
- Distant metastatic disease
- Prior history of more than two doses of neoadjuvant chemotherapy
OT-101 in Combination With Pembrolizumab in Subjects With Malignant Pleural Mesothelioma Failing to Respond to Checkpoint Inhibition
This interventional Phase 2 Trial of TGF-β Inhibition (OT-101) With Anti-PD-1 (Pembrolizumab) is available through the University of Pennsylvania in Philadelphia. The objective is to evaluate the efficacy, safety, and tolerability of various doses of OT-101 in combination with pembrolizumab.
This study will measure the following:
- The overall response rate (ORR) for the combination of OT-101 and pembrolizumab
- The progression-free and overall survival of participants
- The duration of response
Inclusion Criteria
Patients with the following characteristics will be considered for the trial:
- Previous progression of treatment with certain immunotherapies with or without chemotherapy
Exclusion Criteria
Patients with the following characteristics are not eligible for the study.
- History of pneumonitis/interstitial lung disease that has required steroids
Multimodal Therapy
A Study of Immunotherapy Drugs Nivolumab and Ipilimumab in Patients With Resectable Malignant Peritoneal Mesothelioma
This interventional Phase 2 Prospective, Open-label Trial is available through the University of Chicago. The objective is to determine whether giving these two drugs before surgery will decrease live cancer cells and measure whether the regrowth of cancer is consequently slowed.
Participants will receive nivolumab and ipilimumab before and after surgery. A subsequent follow-up period will determine the efficacy of the drugs in removing the cancer. The participant’s overall participation, including drug treatment, surgery, and follow-up visits is expected to last approximately one and a half years.
Researchers will measure the following:
- The major disease response to receiving the combination of immunotherapy drugs prior to surgery
- The percentage of participants who report major side effects after receiving the two drugs prior to surgery
- The number of participants who proceed to surgery without delays after receiving nivolumab and ipilimumab
- The overall survival rate
- The progression-free survival rate
- The percentage of participants who report major side effects when receiving the two drugs after surgery
- The radiologic response to presurgical nivolumab and ipilimumab as measured by radiology images
- The peritoneal carcinomatosis index of participants who received the two drugs presurgically
Inclusion Criteria
Patients with the following characteristics may be eligible to participate:
- Confirmed diagnosis of peritoneal mesothelioma of epithelial, biphasic, or sarcomatoid subtypes
- Disease that may respond to hyperthermic intraperitoneal chemotherapy as determined by a mesothelioma surgeon
- No evidence of visceral metastases
Exclusion Criteria
- Known history of tuberculosis
- Known history of noninfectious pneumonitis that required steroids
- Use of anticoagulation medications that cannot be discontinued for surgery
Neoadjuvant Immune Checkpoint Blockade in Resectable Malignant Pleural Mesothelioma
This Phase 1 and 2 study will evaluate the safety and feasibility of the drugs nivolumab and ipilimumab prior to surgery and for maintenance for one year. It is available at the following locations:
- Greenebaum Comprehensive Cancer Center at the University of Maryland School of Medicine in Baltimore, Maryland
- Johns Hopkins University in Baltimore, Maryland
- University of Texas M.D. Anderson Cancer Center in Houston, Texas
This study will measure the following:
- The safety of neoadjuvant nivolumab in combination with ipilimumab in patients with malignant pleural mesothelioma (MPM) with grade 3 to 4 adverse events
- The feasibility of neoadjuvant nivolumab in combination with ipilimumab in patients with resectable MPM who complete treatment and proceed to surgery
- The pathological response to the two drugs in resected tumor and lymph nodes
- The radiographic response to the combination of drugs
- The toxicity of the combination of drugs
Inclusion Criteria
- Diagnosis of epithelial or biphasic potentially resectable MPM in stages 1 to 3
- Adequate oxygen function
- Serum creatinine within program specifications
- Adequate lung function to permit surgery
Exclusion Criteria
- Unresectable disease or poor surgical candidate
- Pure sarcomatoid disease
- History of symptomatic interstitial lung disease
Neoadjuvant or Palliative Chemotherapy With or Without Immunotherapy for Peritoneal Mesothelioma
This interventional Phase 2 randomized trial is available at numerous locations throughout the U.S. including the following:
- University of Chicago Comprehensive Cancer Center
- Carle Cancer Center in Urbana, Illinois
- University of Kentucky/Markey Cancer Center
- Alliance for Clinical Trials in Oncology in Boston, Massachusetts
- Mayo Clinic in Rochester, Minnesota
- Park Nicollet Clinic in Saint Louis Park, Minnesota
- Ohio State University Comprehensive Cancer Center in Columbus, Ohio
- University of Oklahoma Health Sciences Center in Oklahoma City, Oklahoma
- University of Pittsburgh Cancer Institute in Pittsburgh, Pennsylvania
The objective of this trial is to compare the combination of immunotherapy atezolizumab and the antiangiogenic agent bevacizumab with standard treatment to standard treatment alone. The study will measure the following:
- Treatment response rate
- Major pathologic response rate
- Completeness of cytoreduction
- Conversion to surgical resection among those whose disease was previously deemed unresectable
- The progression-free and overall survival rates
- Adverse events
Inclusion Criteria
- Confirmed malignant peritoneal mesothelioma for which prior treatment has not been tried
Exclusion Criteria
- Uncontrolled infections
Durvalumab With Chemotherapy as First-Line Treatment in Advanced Pleural Mesothelioma
This interventional Phase 3 randomized trial is available in 53 locations throughout the world, including 23 in the U.S. Its objective is to determine whether adding durvalumab to standard chemotherapy improves overall survival in patients with malignant pleural mesothelioma by combining durvalumab with standard chemotherapy, then using durvalumab for maintenance.
The following outcomes will be measured:
- The progression-free survival rate
- The objective tumor response rate
- Side effects
- Health-related quality of life
Inclusion Criteria
- Body weight greater than 30 kg (66 lbs)
- Life expectancy of at least 12 weeks
Exclusion Criteria
- Prior chemotherapy or other systemic cancer treatment for MPM
- Symptomatic or uncontrolled brain metastasis
- Certain abnormal electrocardiogram results
- Certain instances of hearing loss or peripheral neuropathy
Are Clinical Trials Safe?
Every treatment carries risks, whether it is a clinical trial or a standard treatment. According to the ASCO, clinical trials are heavily regulated by several groups of experts, primarily belonging to the following groups:
- An institutional review board: a committee of experts that approves and supervises clinical trials studying human subjects
- Government organizations, including the following:
- The US Department of Health and Human Services
- The Food and Drug Administration
- The National Institutes of Health
- Data and safety monitoring boards, experts who perform the following tasks:
- Review data
- Check on the progress of clinical trials
- Ensure the trial is safe
- Provide the doctors with helpful information
- Perform site visits
- Make recommendations on whether clinical trials should change, stop, or continue
The FDA requires clinical trial investigators to provide prospective participants with complete risk and benefit information. Every participant must sign documentation affirming they have given their informed consent. Participation is always voluntary, and patients have the right to withdraw at any time.
Risks and Benefits of Clinical Trials
A significant amount of research must be completed before humans can participate in clinical studies. Risks are inherent in clinical trials, which are performed to answer medical questions. The American Cancer Society recommends patients carefully weigh the risks and benefits when considering participation.
Benefits
Clinical trials offer the following potential benefits to participants:
- The opportunity to help others by advancing cancer research
- Access to treatment not available elsewhere, which may be safer or more effective than standard treatments
- An increase in treatment options
- An opportunity to play a more active role and feel a deeper sense of control in health-care regimens
- More frequent contact with a cancer treatment team
- Possibility of sponsors covering the cost (not available in all clinical trials)

Risks
Some risks are unavoidable in clinical trials:
- More serious side effects than from standard treatments
- Ineffective results
- Increased doctor visits that could require excess travel
- The possibility of receiving a placebo
- Lack of insurance coverage
Side Effects
Standard cancer treatments are well-known for their side effects, and clinical study participants should be aware that side effects are likely to occur during clinical trials as well.
Chemotherapy
According to the National Institutes of Health, chemotherapy kills healthy cells at the same time as it attacks cancer cells. This can result in the following side effects, which often abate after therapy is completed:
- Mouth sores
- Nausea
- Hair loss
- Fatigue
More serious side effects can include the following:
- Anemia
- Fertility issues
- Infection and neutropenia
- Lymphedema
- Mouth and throat problems
- Sleep problems
- Sexual health issues
- Urinary and bladder issues
- Memory and concentration issues
- Edema
- Delirium
Immunotherapy
The National Institutes of Health warns that side effects can also occur in patients who receive immunotherapy, which revs up the body’s immune system to fight the cancer. Like chemotherapy, the body’s immune system can also attack healthy cells, resulting in such side effects as the following, which vary from person-to-person:
- Skin reactions to the injection site
- Flu-like symptoms
- Fever
- Chills
- Nausea and vomiting
- Headaches
- Fatigue
- Body aches
- Fluid retention, leading to swelling and weight gain
- Heart palpitations
- Sinus congestion
- Infection
- Inflammation of the organs
Considerations Before Participating in a Study
The decision to participate in clinical studies should not be made lightly. The availability of approved treatment options, your current health status, and the urgency of your diagnosis are important factors to consider, among others.
Prognosis
When deciding to participate in a clinical study, it is important to compare the risks and benefits of joining the clinical trial with the risks and benefits of approved treatment options. Questions to consider include the following:
- Will participation in a clinical trial improve or worsen my prognosis?
- What is known about the potential side effects in the clinical trial?
- Are there already effective treatment options?
Many mesothelioma patients find that their treatment options are limited from the beginning or they are quickly exhausted, and they feel they have nothing to lose by participating in a clinical trial. For these patients, the clinical trial may be their last hope.
For some patients, participation in a clinical trial may be motivated by a desire to help others facing similar circumstances when they have lost hope of survival themselves.
Costs
Participation in clinical studies does not necessarily eliminate the cost of treatment. Some studies will be as expensive as conventional treatments, and insurance coverage is not always certain.
Original Medicare does not cover new treatments in clinical trials, but Medicare Advantage Plans do cover certain clinical research studies.
The VA Cooperative Studies Program (CSP) is a research program within the VA’s Office of Research and Development. The CSP works with VA doctors and collaborates with the National Institutes of Health, universities, and the pharmaceutical industry on other clinical trials. This allows eligible veterans to participate in clinical trials that are covered by VA Healthcare.
Other health insurance plans such as group health insurance provided by an employer may cover clinical trials, but this varies. Your plan administrator can determine whether your participation would be covered. In any case, it is always important to speak with your insurer upfront when considering participation in a clinical trial.
All state Medicaid programs are federally mandated to cover routine cancer care in clinical trials. Any additional services provided for data collection purposes in addition to routine cancer care are not covered. When considering participation in a clinical trial, it is important to determine which services are not covered, what the costs will be, and if assistance is available.
Travel
It may be necessary to travel long distances to access clinical trials. This may require extended lodging arrangements in the local area where treatment is available with subsequent trips to the clinic over a period of time. These costs can add up quickly.
Some nonprofit agencies offer free flights to cancer patients who must travel for treatment. The American Cancer Society also offers free lodging throughout the United States. However, the cost is only one consideration.
If your mesothelioma is producing severe symptoms and is in an advanced stage, this could call into question whether you are physically able to make these trips, especially on a repeated basis.
If you are determined to travel to access a clinical trial while facing this situation, you may be able to find a mesothelioma treatment center closer to your local area that offers the same or similar clinical trials. Alternatively, it may be worthwhile to consider temporarily moving to the area.
Term of Treatment
Every study has a prescribed term. The length of treatment could be important, and you may also consider whether you will be able to continue treatment after the study ends if you are benefitting.
What if My Condition Worsens During the Study?
Mesothelioma patients participating in clinical trials typically receive excellent care with vigilant monitoring by the medical care team. The study design will usually include a specific protocol for how this will be handled. In some cases, this could be due to receiving a placebo. In other cases, it could be an indication that the treatment being studied is not effective in your situation.
It is important to ask upfront what the protocol is if the treatment seems to be ineffective or if it appears to be increasing the progression of your condition. Participation is also voluntary, and you are permitted to withdraw from a clinical trial at any time.
Do I Have Options if I Do Not Meet the Eligibility Criteria for Current Clinical Studies?
With the large number of clinical studies available, patients have a reasonable chance of qualifying for participation. However, patients who cannot participate in the available clinical studies may be able to participate in other investigational studies.
Expanded Access
According to Scott Walker, CEO of Prescribe Right LLC, expanded access, also known as compassionate use, allows terminally ill patients who have exhausted standard treatment options and cannot participate in clinical studies to take part in investigational new drug therapies outside of clinical studies. Participation in expanded access programs requires approval from the FDA and an institutional review board.
Right to Try
While many states already had right-to-try laws, a federal law known as Right to Try was passed in 2018. This law allows patients with life-threatening conditions who have exhausted approved treatment options and are unable to participate in a clinical trial to access experimental drugs without approval by the FDA or an institutional review board.
Before patients can access treatment under the federal Right to Try law, the treatment must meet the following criteria:
- Completion of an FDA-approved Phase 1 clinical trial
- Be involved in an active clinical trial or be the subject of an application for approval filed with the FDA
- Be in active development by the manufacturer and not on hold or discontinued
Are Clinical Trials Ever Successful?
If you are considering participating in a clinical trial, it is important to maintain a realistic outlook. While clinical trials offer more treatment options and the possibility of a superior result, they are not more likely than conventional methods to result in a positive outcome. According to ScienceDirect, the majority of drugs tested in clinical trials do not make it to FDA approval.
However, every approved treatment available today is the result of successful clinical trials. Many patients have participated in clinical trials with positive outcomes.
Barbara Grote, a new retiree from Kentucky who was looking forward to a quiet retirement with her horses, was diagnosed with mesothelioma just two months after retiring. The cancer had spread to her heart. She received standard treatment followed by 18 months of treatment in a clinical trial through UC Health in Cincinnati. The treatment was effective, and Barbara Grote resumed her life with her horses eight years later.
While Barbara’s results are not typical, they offer hope that patients who cannot achieve remission through standard treatments may be able to extend their lives through clinical trials. Even if they cannot extend lives, experimental drugs and clinical trials provide hope that one day, mesothelioma will be curable.
